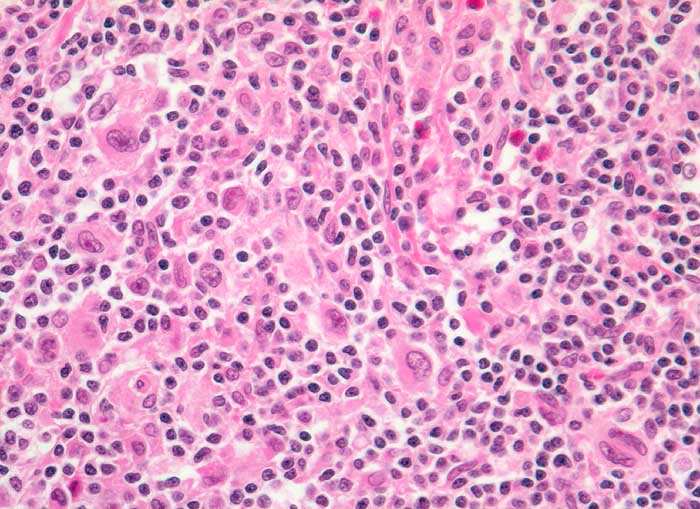

PathoPic – image database / PathoPic ID 5575 - Hodgkin Lymphom noduläre Sklerose
de
Diagnose
Hodgkin Lymphom noduläre Sklerose
Diagnose Gruppe
maligner Tumor
Topographie
Lymphknoten, supraklavikulär
Topographie Gruppe
Lymphatische Gewebe, KM, Milz
Beschreibung
Klinik
Zervikale Lymphadenopathie.
Bilder Typ
Histologie
Vergrösserung
320
Alter
22
Geschlecht
männlich
Datum
Ersteintrag: 23.12.2002
Update: 11.02.2003